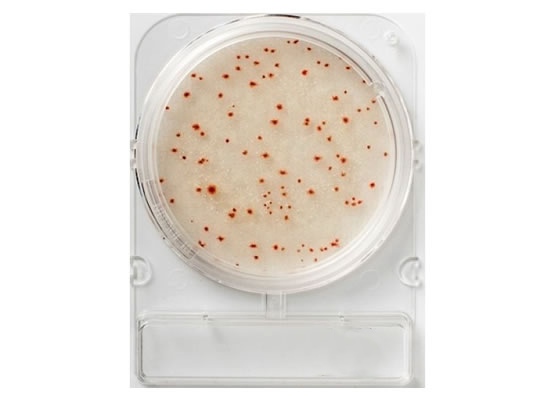

- ANASAYFA
- KURUMSAL
- HAKKIMIZDA
- EĞİTİM ve DANIŞMANLIK
- HABERLER
- Corona Hijyen Ölçümü
- Corona Dezenfeksiyon
- Corona Dezenfeksiyon Ölçümü
- Dezenfektan Kontrol Cihazı
- Bakteri Ölçüm Cihazı
- Virüs Ölçüm Cihazı
- Hijyen Kontrol Cihazı
- ATP Hijyen Monitörü
- Virüs ve Bakteri Kontrolü
- Hazır Besiyeri
- ATP Ölçüm Cihazı
- ADP Ölçüm Cihazı
- AMP Ölçüm Cihazı
- Hastaneler İçin Virüs Ölçüm Cihazı
- Hastaneler İçin Bakteri Ölçüm Cihazı
- Tıbbi Cihazlar Virüs Ölçümü
- Tıbbi Cihazlar Bakteri Ölçümü
- TEMSİLCİLİKLER
- ÜRÜNLER
- VİDEOLAR
- BLOG
- İLETİŞİM
HFS MİKROBİYOLOJİK HİJYEN ÜRÜNLERİ VE HİJYEN ÖLÇÜM CİHAZLARI TİC. LTD. ŞTİ.
HFS Mikrobiyoloji olarak 2006 yılından bu yana başta gıda olmak üzere kozmetik, farmasötik, tarım, kamu ve hizmet sektörü gibi hijyen kontrolü ve mikrobiyolojik analiz yapılan bir çok sektörde, bu kontrollerin sağlanması amacıyla modern ve yenilikçi çözümler sunmaktayız...
MERKEZ
- Kalabak Mah. 3264 Sk. Doğapark Villaları Hfs Taş Ev, Urla / İZMİR
- 0232 766 44 96
- info@hfs.com.tr
ŞUBE
- Torasan Mahallesi 622 Sokak No:10 Urla, İzmir
- 0 (533) 206 72 35
- 0 (533) 206 72 34